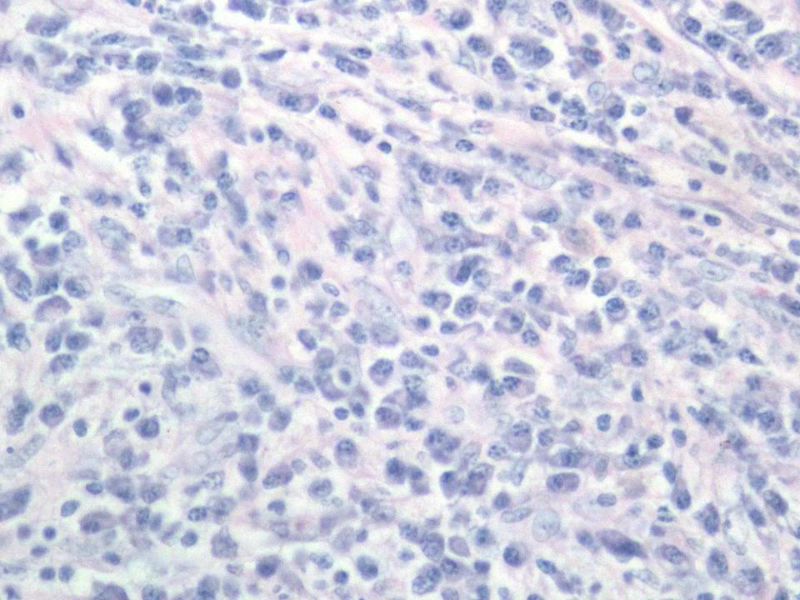
右颌下肿块，新加免疫组化图8
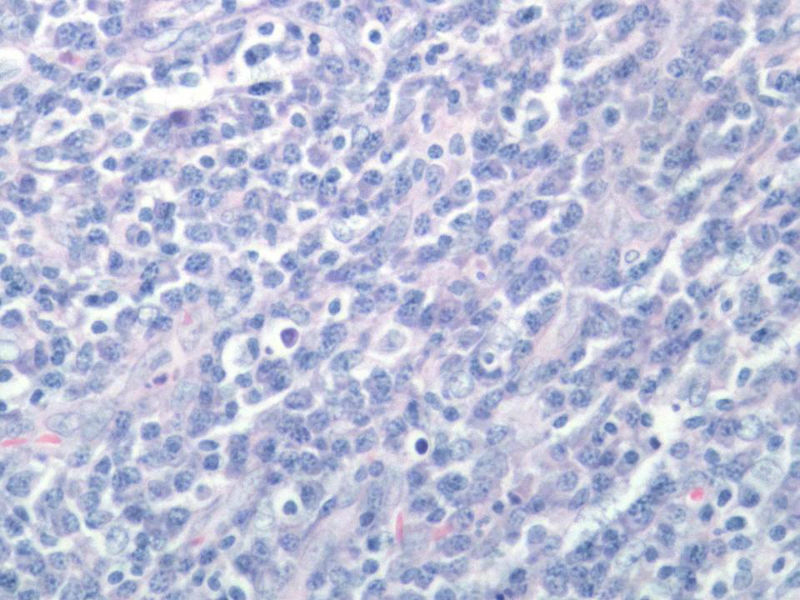
右颌下肿块，新加免疫组化图9
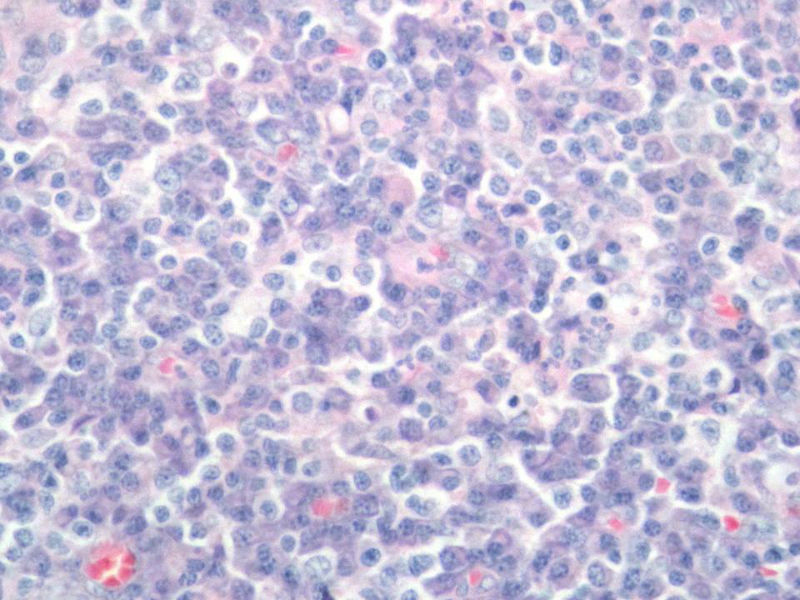
右颌下肿块，新加免疫组化图11
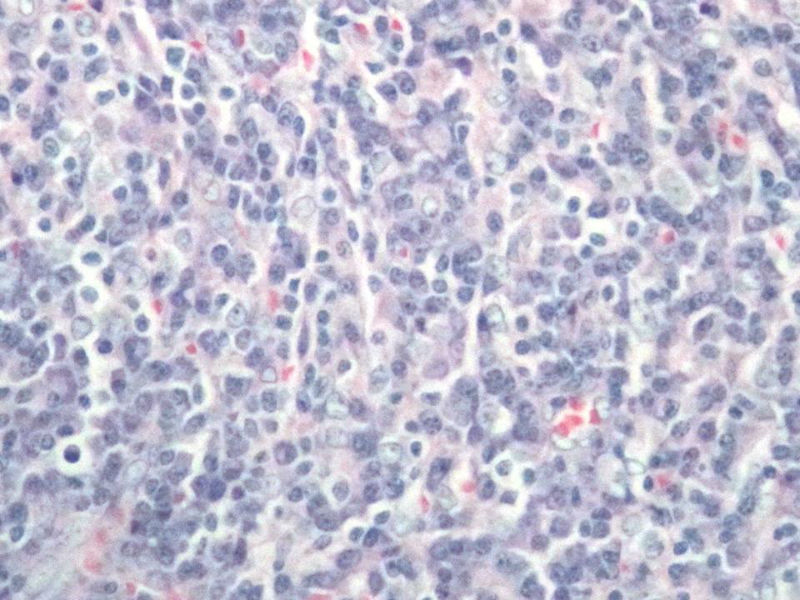
右颌下肿块，新加免疫组化图12
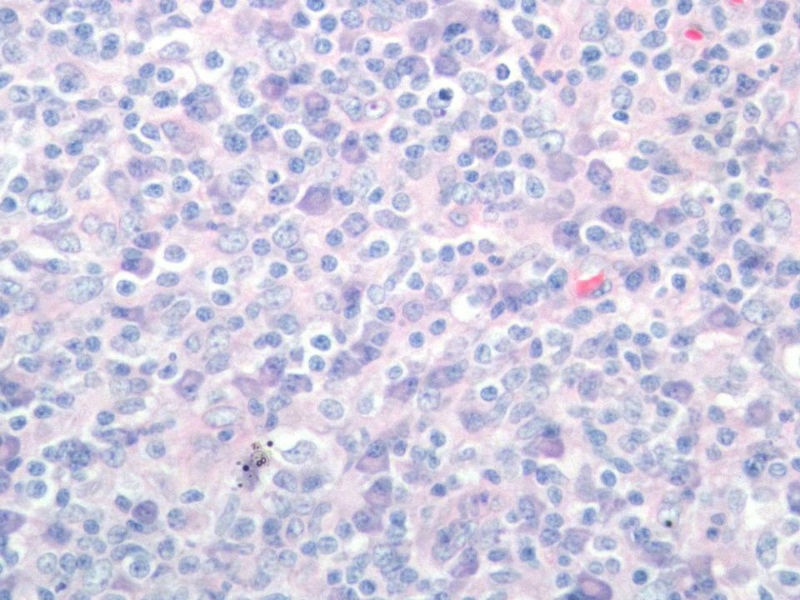
右颌下肿块，新加免疫组化图16

| 图片: | |
|---|---|
| 名称: | |
| 描述: | |
- 右颌下肿块,新加免疫组化
女,56岁,右颌下肿块两月余,检查肿块活动度差,手术切除。肉眼,灰白类圆形肿物,2X2X1厘米。包膜不完整,切面灰白色,质软。

名称:图1
描述:幻灯片1

名称:图2
描述:幻灯片2

名称:图3
描述:幻灯片3

名称:图4
描述:幻灯片4

名称:图5
描述:幻灯片5

名称:图6
描述:幻灯片6

名称:图7
描述:幻灯片7
名称:图8
描述:幻灯片8
名称:图9
描述:幻灯片9

名称:图10
描述:幻灯片10
名称:图11
描述:幻灯片11
名称:图12
描述:幻灯片12

名称:图13
描述:幻灯片13

名称:图14
描述:幻灯片14

名称:图15
描述:幻灯片15
名称:图16
描述:幻灯片16

名称:图17
描述:幻灯片17
标签:
-
本帖最后由 xclbljys 于 2011-11-12 17:55:52 编辑

- 许春雷
×参考诊断
与经治医生交流,患者目前一般状态良好,体表未触及肿块,CT各主要器官未见病变。结合免疫组化,我们考虑为浆细胞肉芽肿,但这个部位发生罕见,请指点!谢谢!

名称:图1
描述:幻灯片2

名称:图2
描述:幻灯片3

名称:图3
描述:幻灯片4

名称:图4
描述:幻灯片5

名称:图5
描述:幻灯片6

名称:图6
描述:幻灯片7

名称:图7
描述:幻灯片8

名称:图8
描述:幻灯片9

名称:图9
描述:幻灯片10

名称:图10
描述:幻灯片11

名称:图11
描述:幻灯片12

名称:图12
描述:幻灯片13

名称:图13
描述:幻灯片14

名称:图14
描述:幻灯片15

- 许春雷
-
chenliu0552 离线
- 帖子:502
- 粉蓝豆:22
- 经验:985
- 注册时间:2010-12-10
- 加关注 | 发消息
-
chenliu0552 离线
- 帖子:502
- 粉蓝豆:22
- 经验:985
- 注册时间:2010-12-10
- 加关注 | 发消息
-
chenliu0552 离线
- 帖子:502
- 粉蓝豆:22
- 经验:985
- 注册时间:2010-12-10
- 加关注 | 发消息
-
本帖最后由 chenliu0552 于 2011-11-14 10:22:59 编辑
能产生显著淋巴滤泡的一些病变在很多专著甚至教科书中都有比较一致的描述。浆细胞肉芽肿的概念本身就有很多争议,WHO呼吸系统和软组织分册均将其归为炎性肌纤维母细胞瘤的同义词,似乎强调梭形细胞在其诊断中的意义。如果浆细胞肉芽肿是最合适的名称的话,那也是少见病例发生在少见部位并有不典型的形态学表现。
另外,网络读片不能完整地看到肿块的结构,肿块能否定是淋巴结吗?如果是淋巴结,我个人没有淋巴结浆细胞肉芽肿的读片经验,能不能考虑或排除一下浆细胞型的castleman或其它?
个人认识肤浅,理解不透彻,所以问题很多,谢谢!
-
chenliu0552 离线
- 帖子:502
- 粉蓝豆:22
- 经验:985
- 注册时间:2010-12-10
- 加关注 | 发消息
-
wangdingding 离线
- 帖子:1474
- 粉蓝豆:98
- 经验:6042
- 注册时间:2006-10-19
- 加关注 | 发消息
-
chenliu0552 离线
- 帖子:502
- 粉蓝豆:22
- 经验:985
- 注册时间:2010-12-10
- 加关注 | 发消息
-
chenliu0552 离线
- 帖子:502
- 粉蓝豆:22
- 经验:985
- 注册时间:2010-12-10
- 加关注 | 发消息





























